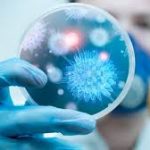

If you are one of the millions of Americans who planted or expanded your garden this spring when the pandemic hit our shores, you might be dealing with an overabundance of produce coming from your garden. Oops, you planted WAY too many cucumbers and zucchinis. They’re coming out your ears. Speaking of ears, now that you’ve been eating sweet corn every day for the past three weeks, you could be getting tired of it.
After all of that hard work watering, fertilizing, dealing with weeds, and pests, you’ve spent far too much time on your garden to let your hard-earned success to go to waste. Here are some options on how to handle your bounty.
- Eat it. Nothing beats fresh-from-the-garden. Savor you hard work and eat as much as you can within days of harvesting. Here are 30 recipes to use fresh tomatoes.
- Give surplus to friends. Nobody can use dozens of 10 pound zucchini’s, but you can pawn a few off here and there to friends or co-workers for zucchini bread or noodles or whatever. Add some tomatoes to your gift so it doesn’t look like you’re just dumping zucchini.
- Freeze your extra goods. Most garden items can be frozen if prepped properly. If you have extra freezer space, this is a good option.
- Can it. Canning is an ideal long-term way to store foods. Wasn’t that what your garden was all about? Saving up stuff in case there’s another COVID-19 shortage? Canning is ideal for most produce like beans, carrots and beets. Many other foods can also be excellent candidates for canning (with proper preparation), including tomato sauces, salsa, applesauce, and more.
My kid made a fairly large batch of salsa last week and reported difficulty finding basic canning items. Many stores around Billings had low, or no inventory on various lids, racks, large pots, jars, and other miscellaneous items necessary for a canning run. If Wal-Mart or your favorite grocery store are out of supplies, you can also check places like Billings Hardware and our local Ace Hardware stores. Check back frequently, as items seem to go fast when the new shipments arrive.
You might have issues finding certain spices. I was hoping to make a batch of refrigerator pickles this week (skipping the entire canning process) and had trouble finding the recipe’s ingredients. Mixed peppercorns were out, as were mustard seeds and the pickling mix. Some places didn’t have pickling salt either, although I did find fresh dill sprigs. I should have bought them, because they’re probably gone now.